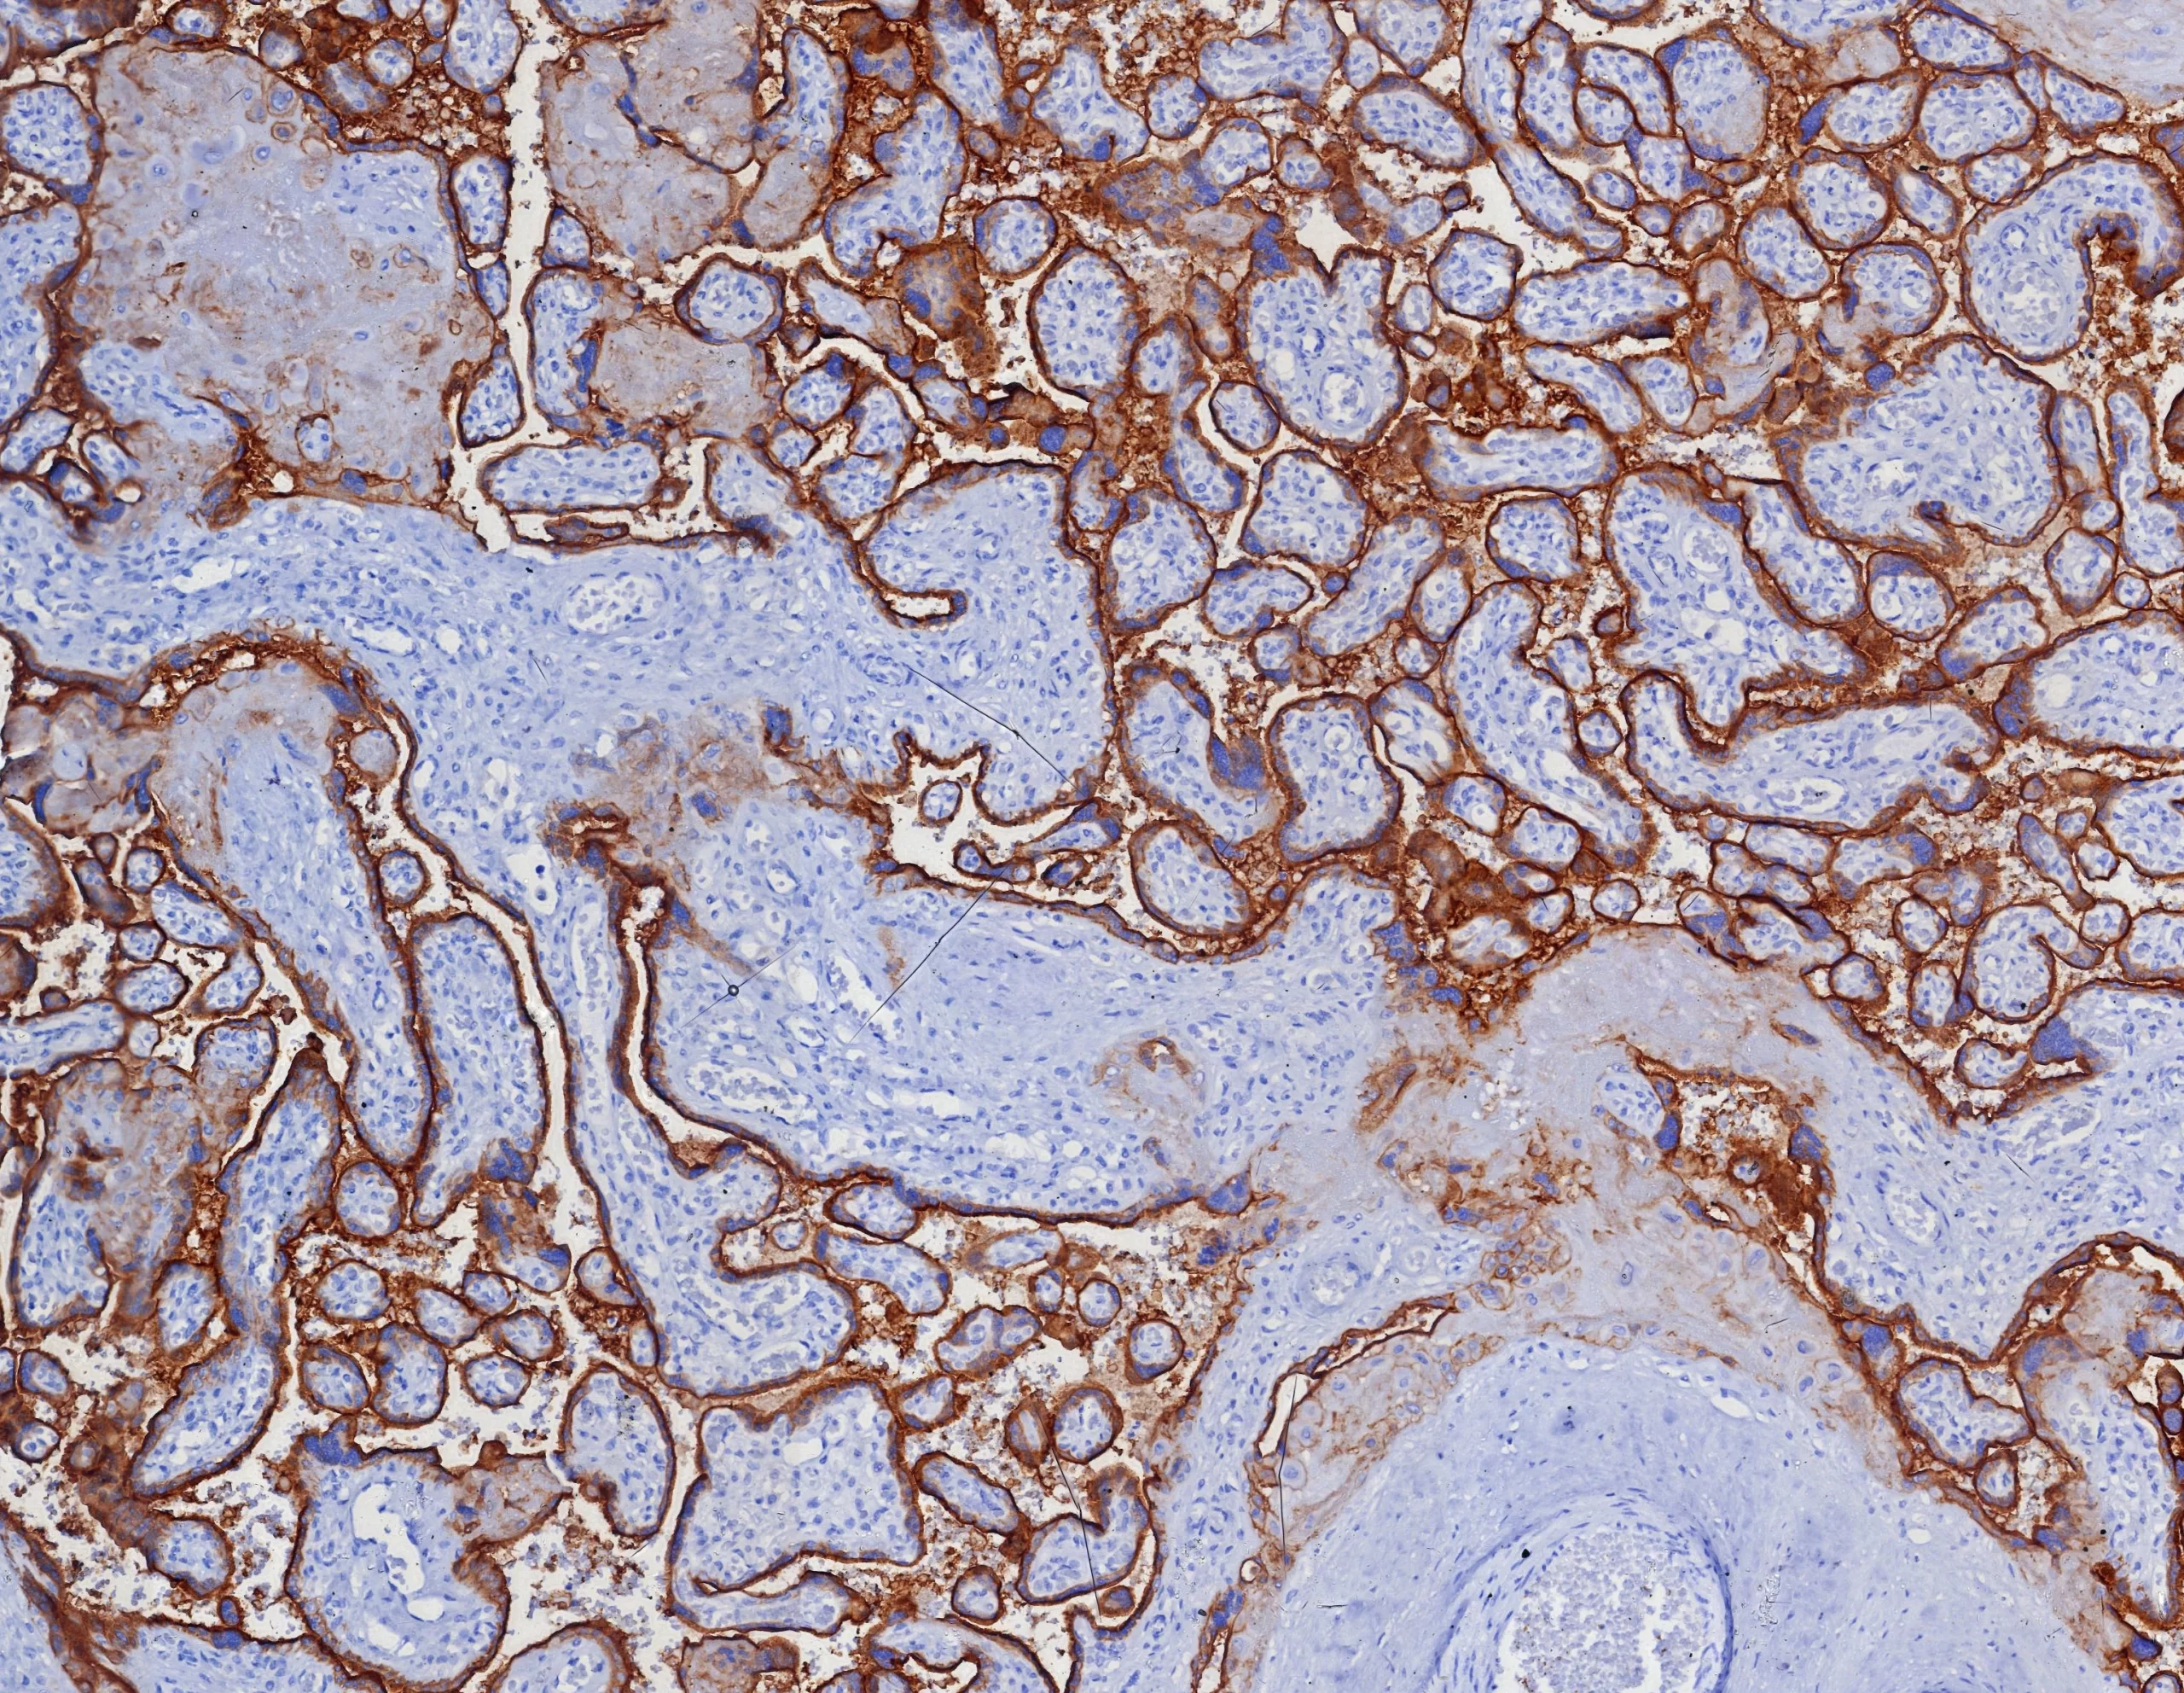

Formalin-fixed, paraffin-embedded human placenta stained with PD-L1 Recombinant Rabbit Monoclonal Antibody (PDL1/4280R).

Formalin-fixed, paraffin-embedded human placenta stained with PD-L1 Recombinant Rabbit Monoclonal Antibody (PDL1/4280R).

IHC analysis of formalin-fixed, paraffin-embedded human brain. Negative tissue control using PDL1/4280R at 2ug/ml in PBS for 30min RT. HIER: Tris/EDTA, pH9.0, 45min. 2 °: HRP-polymer, 30min. DAB, 5min.

SDS-PAGE Analysis Purified PD-L1 Recombinant Rabbit Monoclonal Antibody (PDL1/4280R). Confirmation of Purity and Integrity of Antibody.

Formalin-fixed, paraffin-embedded human lung SqCC stained with PD-L1 Recombinant Rabbit Monoclonal Antibody (PDL1/4280R).
PD-L1 is a checkpoint regulator in immune cells, it is expressed on immune or non-hematopoietic cells. Expression of the protein is seen during pregnancy where it has a role in suppressing the immune system. PD-L1 induces an inhibitory signal in activated T-cells and promotes T-cell apoptosis. It is overexpressed in a number of different cancers where it is believed to play a significant role in the cancer s ability to evade the immune system.
There are no reviews yet.